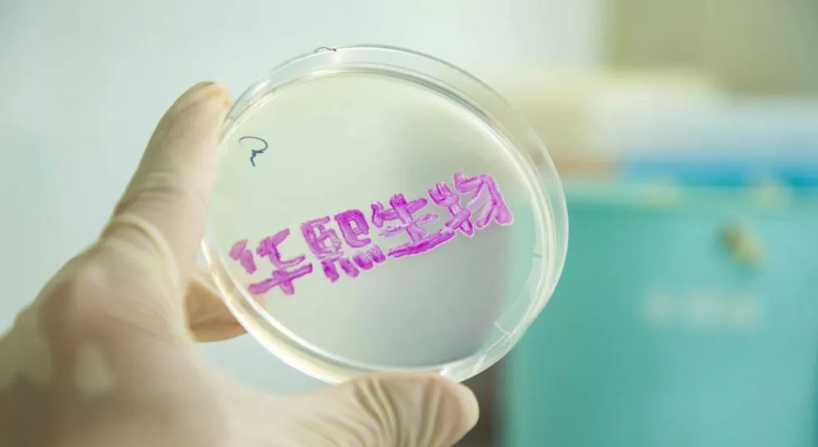
Top social|数播|social|Kol|KOL|kol平台|kol投放|kol投放平台|kol营销平台|华熙生物|李宁|携程|京东|雅诗兰黛|腾讯|ChatGPT|AI智能应用|人工智能|kol接单平台|kol投放网站|kol资源|小红书kol推广|kol采购平台|kol资源平台|快手|小红书kol|微博kol|微博kol推广|抖音|媒介投放

过去半年多,ChatGPT爆红,带火AI大模型,业界人士认为,AI已经从1.0时代进入2.0时代,一场真正的划时代性技术变革,正在发生。
AI浪潮席卷而来之时,没有人能够置身事外,从北上广到小县城,AI已经“无孔不入”,当一个比互联网更大的机会出现时,谁也不想错过这一股浪潮。时刻瞄准商机的公司CEO们,更是既兴奋、又焦虑,兴奋的是新变革意味着新机遇,同时他们也焦虑在这一场巨变中会被落下。
想体验ChatGPT还没找到入口的,可以直接复制链接到浏览器打开试用:https://gpt.topsocial.com.cn/

提到华熙生物,你会想到什么?是玻尿酸巨头,抑或是润百颜、夸迪、次抛精华?事实上,这家科创板生物科技公司虽是以透明质酸起家,但随着合成生物技术发展,华熙生物的新原料版图已拓展到麦角硫因、依克多因、胶原蛋白等众多品类,为其业绩增长贡献了新动能。
近日,华熙生物发布了2023年半年报:报告期营收30.76亿元,其中原料业务收入5.67亿元,同比增长23.20%。收入结构方面,非透明质酸原料业务保持了较高的增速。
8月,港股国产运动品牌迎来疫情放开后首个财报季。李宁、安踏集团、特步集团和361°四家企业一改疫情期间普升或普降的态势,出现了业绩分化。
净利润增幅只有李宁为负,同比下跌3.1%至21.21亿元,不过,公司15.1%的净利率仍处在行业健康水平,略低于安踏集团和361°,比特步集团高了近5个百分点。

腾讯入股金融科技企业盟浪
天眼查资料显示,近日,盟浪可持续数字科技 有限责任公司发生工商变更,新增广西腾讯创业投资有限公司为股东,同时公司注册资本由约1677万元增至约1825万元。
该公司成立于2021年,法定代表人为白虹,经营范围包含:软件开发、信息技术咨询服务、人工智能基础软件开发、计算机系统服务等。公开信息显示,该公司是一家聚焦可持续发展价值量化评估的金融科技企业。
携程国庆前瞻:国内游预订同比增5倍 长线游订单占比84%
据携程数据显示,截至9月6日,国内旅游产品预订量同比去年增长近5倍,最近一周下单量环比上周增长63%。机票、民宿等业态的周环比增长均超过50%,景区门票则翻倍上涨。
截至8月30日,携程大交通市场搜索指数显示:2023年国庆假期的境内机票搜索热度超过2022年同期190%以上,恢复至2019年同期104%;住宿行业的火爆程度尤在大交通之上,假期境内酒店市场搜索热度已达2022年十一同期4倍以上,相较2019年十一同期增长近120%。
京东老酒频道将在9月中下旬上线
京东超市近日宣布,京东老酒频道将在9月中下旬上线。
产品覆盖超过生产日期五年及以上的白酒、洋酒、露酒、黄酒,涉及17大名酒、53大优质酒及三大洋酒等知名品牌,并以“年份陈年酒、亲民陈年酒、稀缺套装”三大类分层为核心,满足用户在收藏、礼赠、宴请、投资等场景的需求。
雅诗兰黛首次投资中国美妆品牌 透露在华下一步动作
国产美妆品牌codemint正式宣布获得雅诗兰黛集团早期投资和孵化风险投资公司New Incubation Ventures的少数股权融资,具体合作细节未披露。
据了解,codemint创立于2021年,创始人系流量网红周扬青,这是雅诗兰黛第一次投资国产美妆品牌。雅诗兰黛集团早期投资和孵化部门全球高级副总裁 Shana Randhava表示,未来雅诗兰黛会继续加大对中国市场的投资。
素材均来自网络,侵删